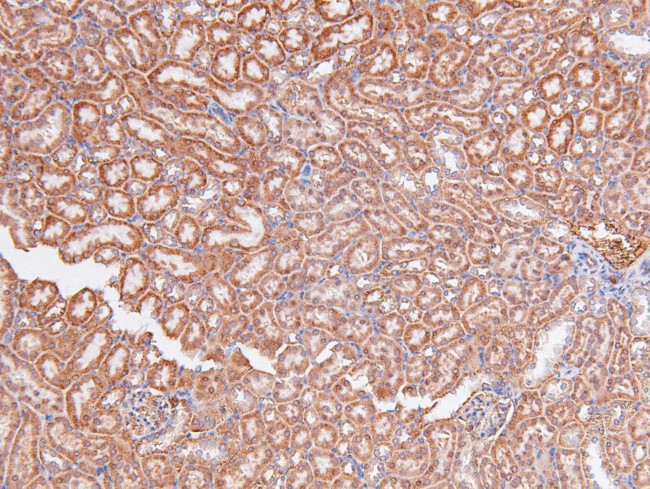
Phospho-A-Raf (Ser299) Antibody in Immunohistochemistry (Paraffin) (IHC (P))

Search
Invitrogen
Phospho-A-Raf (Ser299) Polyclonal Antibody
{{$productOrderCtrl.translations['antibody.pdp.commerceCard.promotion.promotions']}}
{{$productOrderCtrl.translations['antibody.pdp.commerceCard.promotion.viewpromo']}}
{{$productOrderCtrl.translations['antibody.pdp.commerceCard.promotion.promocode']}}: {{promo.promoCode}} {{promo.promoTitle}} {{promo.promoDescription}}. {{$productOrderCtrl.translations['antibody.pdp.commerceCard.promotion.learnmore']}}
图: 1 / 4
Phospho-A-Raf (Ser299) Antibody (PA5-105865) in IHC (P)




产品信息
PA5-105865
种属反应
宿主/亚型
分类
类型
抗原
偶联物
形式
浓度
规格
纯化类型
保存液
内含物
保存条件
运输条件
RRID
产品详细信息
Antibody detects endogenous levels of A-RAF only when phosphorylated at Ser299.
靶标信息
Several serine/threonine protein kinases have been implicated as intermediates in signal transduction pathways. These include ERK/MAP kinases, ribosomal S6 kinase (Rsk) and Raf-1. Raf-1 is a cytoplasmic protein with intrinsic serine/threonine activity. It is broadly expressed in nearly all cell lines tested to date and is the cellular homolog of v-Raf, the product of the transforming gene of the 3611 strain of murine sarcoma virus. The unregulated kinase activity of the v-Raf protein has been associated with transformation and mitogenesis while the activity of Raf-1 is normally suppressed by a regulatory N-terminal domain. A-Raf, a second member of the Raf gene family of serine/ threonine protein kinases, exhibits substantial homology to Raf-1 within the kinase domain of the two molecules, but less homology elsewhere. Expression of A-Raf is found at highest levels in urogenital tissues and kidney and at lowest level in brain tissue.
仅用于科研。不用于诊断过程。未经明确授权不得转售。
篇参考文献 (0)
生物信息学
蛋白别名: A-Raf proto-oncogene serine/threonine-protein kinase; A-raf-1; Oncogene ARAF1; Proto-oncogene A-Raf; Proto-oncogene A-Raf-1; Proto-oncogene Pks; raf a; Raf related protein; raf-related oncogene; Ras-binding protein; Ras-binding protein DA-Raf; RP1-230G1.1; Serine/threonine-protein kinase A-Raf; unnamed protein product; v-raf murine sarcoma 3611 viral oncogene homolog 1; v-raf murine sarcoma 3611 viral oncogene-like protein; v-raf oncogene homolog 1 (murine sarcoma 3611 virus)
基因别名: 1200013E08Rik; A-RAF; ARAF; ARAF1; AW495444; PKS; PKS2; RAFA1
UniProt ID: (Human) P10398, (Rat) P14056, (Mouse) P04627
Entrez Gene ID: (Human) 369, (Rat) 64363, (Mouse) 11836